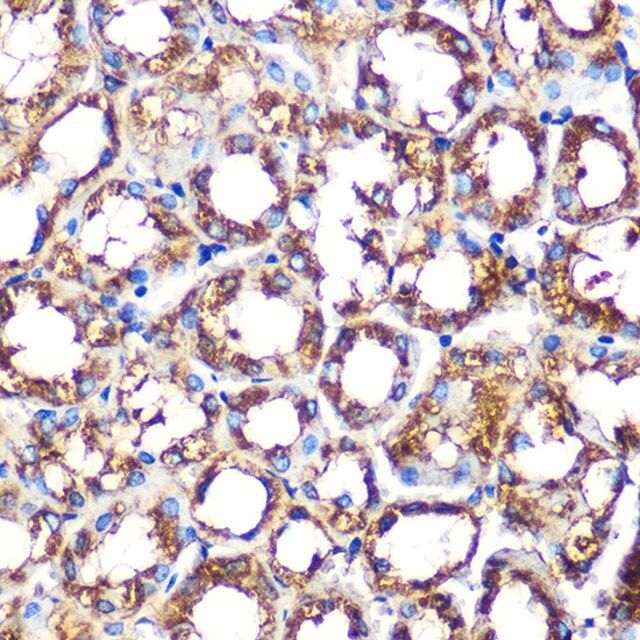

您的位置:首页 > 半岛bd体育手机客户端
中心 > Anti-NOXA2/p67phox antibody produced in rabbit
Anti-NOXA2/p67phox antibody produced in rabbit
半岛bd体育手机客户端
性质
| biological source【生物来源】 | rabbit |
| Quality Level【质量水平】 | 100 |
| antibody product type | primary antibodies |
| clone【克隆】 | monoclonal |
| form【形式】 | liquid |
| species reactivity | mouse, human |
| concentration【浓度】 | 0.55 mg/mL |
| technique(s) | immunohistochemistry: 1:50-1:200 western blot: 1:500-1:2000 |
| UniProt accession no.【UniProt登记号】 | P19878 |
| shipped in【运输】 | wet ice |
| storage temp.【储存温度】 | −20℃ |
| Gene Information | human ... NCF2(4688) |
基本信息
| General description【一般描述】 | This gene encodes neutrophil cytosolic factor 2, the 67-kilodalton cytosolic subunit of the multi-protein NADPH oxidase complex found in neutrophils. This oxidase produces a burst of superoxide which is delivered to the lumen of the neutrophil phagosome. Mutations in this gene, as well as in other NADPH oxidase subunits, can result in chronic granulomatous disease, a disease that causes recurrent infections by catalase-positive organisms. Alternative splicing results in multiple transcript variants encoding different isoforms. [provided by RefSeq, Jun 2010] |
| Immunogen【免疫原】 | A synthesized peptide derived from human NOXA2/p67phox |
| Physical form【外形】 | Buffer: PBS with 0.02% sodium azide,0.05% BSA,50% glycerol,pH7.3. |





